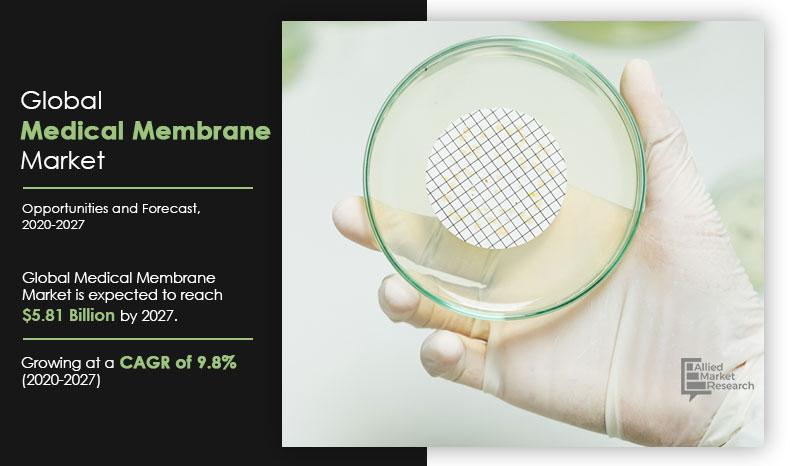
Medical-Membrane-Market,-2020-2027

Medical Membrane Market Outlook - 2027
The global medical membrane market was valued at $2.73 billion in 2019, and is projected to reach $5.81 billion by 2027, growing at a CAGR of 9.8% from 2020 to 2027.
Membrane technology is of major importance in medical applications, in particular in a number of lifesaving treatment methods. Its major medical applications include drug delivery; tissue regeneration; artificial organs; and diagnostic devices, such as medical device coatings and bio-separations. The membrane is used to cover some of the improved applications of membrane technologies, such as concentration, separation, and purification, as a separation technique. Medical membranes have high precision for separation and assist in the processing of products of high purity. In addition, they provide comparatively greater selectivity toward the critical components and thus help to improve wastewater treatment. Owing to increase in their application across various end-use industries, such as biotechnology, pharmaceutical, and healthcare, the global medical membrane market has witnessed unprecedented growth in recent years.
Rise in prevalence of diseases globally; developments in biotechnology, life science, and healthcare industries, surge in demand for high-purity products, increase in medical membrane consumption in the medical industry are some of the key driving forces of the global medical membrane industry. In addition, in the last few years, there have been growing cases of end-stage renal disease and diabetes due to upsurge in geriatric population and increase in the number of obese people worldwide. The pharmaceutical, healthcare, and biotechnology industries are experiencing tremendous growth in developing countries as the ageing population rises. Furthermore, development of the healthcare industry in emerging economies is expected to provide lucrative opportunities for business growth during the forecast period.
The global medical membrane market is segmented into material, technology, application, and region. Depending on material, the market is divided into acrylics, polypropylene (PP), polyvinylidene fluoride (PVDF), polysulfone (PSU) & polyether sulfone (PESU), polytetrafluoroethylene (PTFE), and others. Depending on technology, the market is categorized into microfiltration, ultrafiltration, nanofiltration, dialysis, gas filtration, and others. By application, it is divided into pharmaceutical filtration, IV infusion & sterile filtration, bio-artificial processes, drug delivery, hemodialysis, and others. Region wise, it is studied across North America, Europe, Asia-Pacific, and LAMEA.
The manufacturers studied and profiled in the global medical membrane market are Amniox Medical, Asahi Kasei, Danaher Corporation, Hangzhou Cobetter Filtration Equipment, Koch Membrane Systems, Merck Group, Mann+Hummel, Sartorius AG, W. L. Gore & Associates, and 3M Company.
Global Medical Membrane Market, by Material
By material, polysulfone (PSU) & polyether sulfone (PESU) has emerged as the largest segment in the global market for medical membrane. The widespread use of this form of material to remove particulates during general filtration and its low protein and drug binding characteristics make it ideal for various end-user sectors such as the biotechnology, pharmaceutical, life sciences, and healthcare industries contributes to the revenue generated by this segment.
By Material
Polysulfone (PSU) & Polyether Sulfone (PESU) is projected as the most lucrative segment.
Global Medical Membrane Market, by Technology
By technology, the nanofiltration segment dominates the global market. This is attributed to the fact that with increase in flow rates, nanofiltration is achieved at reduced operating pressures. The applicability of nanofiltration in new areas such as pharmaceuticals and fine chemicals has been extended by research & development of solvent-stable membranes, thus driving the growth of the nanofiltration segment.
By Technology
Nanofiltration is projected as the most lucrative segment.
Global Medical Membrane Market, by Application
By application, the pharmaceutical filtration segment garnered the largest share, in terms of revenue. High rate of occurrence of renal diseases, advances in medical technology, development of pharmaceutical & healthcare industries, and rise in demand for high-purity materials & medicines are driving the growth of the pharmaceutical filtration segment.
By Application
Pharmaceutical filtration is projected as the most lucrative segment.
Medical Membrane Market, by Region
By region, Europe is a significant contributor to the global demand for medical membrane. Its growth is fueled by the growing end-stage renal disease (ESRD) patient pool, increasing availability of better diagnosis facilities, and high incidence and prevalence of chronic diseases such as diabetes and hypertension.
By Region
Europe holds a dominant position in 2019 and would continue to maintain the lead over the forecast period.
Key Benefits For Stakeholders
- The report provides an in-depth analysis of the medical membrane market forecast along with the current trends and future estimations.
- This report highlights the key drivers, opportunities, and restraints of the market along with the impact analyses during the forecast period.
- Porter’s five forces analysis helps analyze the potential of the buyers & suppliers and the competitive scenario of the global medical membrane industry for strategy building.
- A comprehensive medical membrane market analysis covers factors that drive and restrain market growth.
- The qualitative data in this report aims on medical membrane market dynamics, trends, and developments.
Medical Membrane Market Report Highlights
| Aspects | Details |
| By Material |
|
| By Technology |
|
| By Application |
|
| By Region |
|
| Key Market Players | Mann+Hummel, Koch Membrane Systems, Merck Group, W. L. Gore & Associates, Hangzhou Cobetter Filtration Equipment, Sartorius AG, Amniox Medical, 3M Company, Danaher Corporation, Asahi Kasei |
Analyst Review
The global medical membrane market is moving toward growth stabilization phase in its industry life cycle. The factors driving the growth of the global market for medical membrane are surge in demand from the pharmaceutical filtration, IV infusion & sterile filtration, drug delivery, and hemodialysis sectors. In 2019, the polysulfone (PSU) & polyether sulfone (PESU) segment garnered the largest market share of 34.8%. High demand for PSU & PESU is attributed to the properties of these materials and their growing demand for the application of pharmaceutical filtration and hemodialysis. During the forecast period, the nanofiltration (NF) segment is expected to witness the highest growth rate of 29.2%,. owing to potential medical and biological applications, which include isolating, sensing, sorting, & releasing biological molecules and increase in awareness about its applicability.
The pharmaceutical filtration segment occupied the largest market share of 31.0% in 2019. Rise in drug production and a strong biologics pipeline are expected to fuel the growth of the global pharmaceutical membrane filtration market. However, in terms of market sales, North America is the largest market for medical membranes, followed by Western Europe and the Asia-Pacific. U.S. and Germany are the leading medical membrane markets in North America and Western Europe, respectively.
Increasing use of medical membranes owing to, growing need for high-purity selective separation in various end-use applications is a major factor driving growth of the global medical membranes market.
The market value of medical membrane in the forecast period is anticipated to be $5.81 Billion.
Hangzhou Cobetter Filtration Equipment, Koch Membrane Systems, Merck Group, Mann+Hummel, Sartorius AG, W. L. Gore & Associates, and 3M Company are the top companies in the medical membrane industry
Pharmaceutical filtration application is projected to increase the demand for medical membrane market
Material is the leading segment in this market
The expansion of pharmaceutical and healthcare industries is expected to boost demand for medical membranes, thus boosting the growth of the global market during the projected period.
Increase in incidence of diabetes and kidney disease is expected to fuel the demand for medical membranes in hemodialysis applications, there by driving the growth of the overall market.
Owing to the outbreak of the COVID-19 pandemic, the global medical membrane market is expected to witness a slowdown during the next couple of years. However, rise in need for medical membranes in the healthcare industry, being an essential service, is expected to boost the growth of the global market during the forecast period.
Loading Table Of Content...